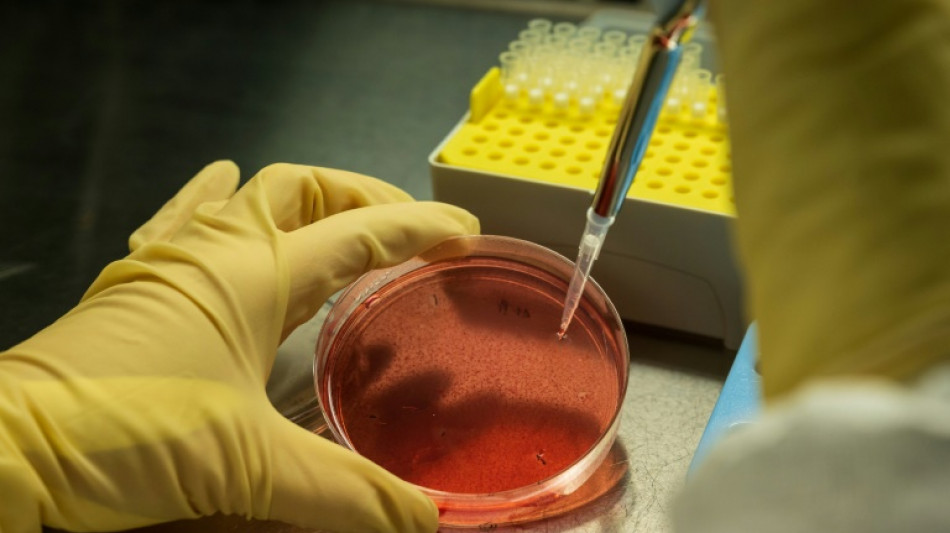
Des scientifiques appellent à la prudence envers les biotechnologies génétiques

Des scientifiques appellent à la prudence envers les biotechnologies génétiques
Plus de 100 scientifiques et experts du monde entier appellent vendredi les dirigeants internationaux à interdire la diffusion dans la nature d'organismes modifiés par des biotechnologies génétiques, en pleine 15e Conférence des Nations unies sur la biodiversité (COP15).
Dans une tribune, rédigée à l'initiative de l'ONG française Pollinis et présentée à Montréal vendredi, les scientifiques (écologues, biologistes moléculaires, généticiens etc.) demandent le "respect du principe de précaution" à l'échelle mondiale "tant que les preuves n’auront pas été réunies établissant l'innocuité des effets directs et indirects d’une application de ces nouvelles biotechnologies génétiques, et de leurs produits, organismes et composants".
"Ces biotechnologies pourraient nuire aux populations d'insectes pollinisateurs et précipiter leur déclin" alors même qu'ils sont "essentiels à la biodiversité, aux fonctions écosystémiques, et augmentent le rendement des cultures", argumentent-ils.
Les négociations de la COP15, qui dureront jusqu'au 19 décembre, portent notamment sur ce sujet. Leur issue pourrait mener soit vers une plus grande régulation soit au contraire vers une facilitation de leur usage.
- Controverse -
Indifféremment appelées NGT (new genomic techniques), ou NBT (new breeding techniques pour "nouvelles techniques de sélection"), une kyrielle de nouveaux outils d'édition génomique (Crispr-Cas9, Talen etc.) modifiant le matériel génétique d'êtres vivants ont émergé ces dernières années et ciblent en priorité les insectes et les plantes.
A la différence des OGM dits "transgéniques" qui introduisent un gène extérieur dans une plante ou un animal, ces nouvelles techniques permettent de modifier le génome d'un être vivant, sans ajout extérieur.
Leurs détracteurs parlent d'"OGM cachés" ou de "nouveaux OGM" et craignent des effets néfastes sur la biodiversité. Mais leurs partisans les voient comme des solutions pour la santé humaine, l'agriculture ou la conservation des espèces.
L'un des projets-phares est développé par la Fondation Bill & Melinda Gates pour rendre les moustiques femelles stériles au moyen de la technique du "forçage génétique" qui consiste à insérer une modification génétique sur les deux allèles d'un chromosome pour s'assurer que la modification soit transmise à l'ensemble des descendants. L'objectif est d'éradiquer le paludisme, dont les moustiques sont le vecteur, en Afrique.
Les NGT permettent également le "silençage génétique" qui inhibe certaines expressions génétiques chez les animaux ou les plantes. Les principaux poids lourds de l'agro-industrie, Bayer-Monsanto ou Syngenta, travaillent à l'élaboration de pesticides en spray d'ARN dit "interférent" qui iront neutraliser l'expression de certains gènes d'insectes. Cela permettrait de lutter contre des ravageurs de cultures tels que le doryphore qui décime les cultures de pommes de terre ou la drosophile asiatique qui s'attaque aux arbres fruitiers.
- Du labo au champ -
En ce qui concerne les plantes, l'utilisation des NBT permettrait d'"améliorer les plantes" en "les rendant résistantes à des virus, aux herbicides, ou de réduire leur stress hydrique", explique Christophe Robaglia, professeur en biologie à l'université Aix-Marseille et expert OGM auprès de l'Autorité européenne de sécurité des aliments.
Les défenseurs de ces NBT réclament l'autorisation de sortir ces technologies des laboratoires et de mener des essais en plein champ, notamment en Europe où ils tombent sous le coup de la règlementation des OGM dits transgéniques.
Dans l'Union européenne, le maïs MON810 de Monsanto résistant aux insectes est le seul OGM autorisé à la culture. Les produits issus des biotechnologies bénéficient d'un cadre beaucoup plus souple aux Etats-Unis, au Canada, en Argentine, au Brésil, au Japon et en Inde, notamment.
"La question n'est pas d'être pour ou contre, ce sont de simples techniques. Ce qui compte c'est l'application que l'on peut en faire et qu'il faut encadrer", ajoute M. Robaglia qui dénonce des règlements européens "obsolètes" sur les OGM et les NBT.
- Moratoire -
C'est l'utilisation de ces techniques sur les insectes qui est la plus controversée.
Les scientifiques signataires de l'appel craignent la propagation et en particulier des "transferts horizontaux de gènes" vers des espèces non-cibles, déséquilibrant les interactions entre espèces et donc l'ensemble de la biodiversité.
"Il est impossible d'intervenir sur le génome d'un individu sans interagir avec l'ensemble de son espèce, des autres espèces et plus largement avec l'ensemble du vivant", prévient Nicolas Laarman, délégué général de Pollinis.
Les délégués de la COP15 ont encore 10 jours pour discuter d'un éventuel moratoire.
V.Barbieri--IM




